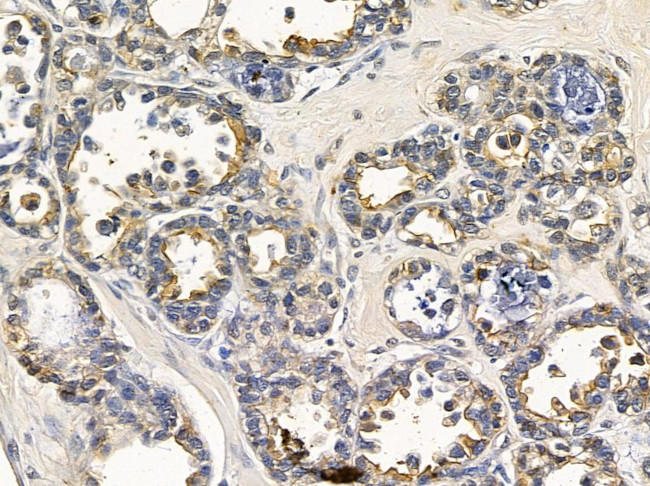
SCN4A Antibody in Immunohistochemistry (Paraffin) (IHC (P))

Search
Invitrogen
SCN4A Polyclonal Antibody
{{$productOrderCtrl.translations['antibody.pdp.commerceCard.promotion.promotions']}}
{{$productOrderCtrl.translations['antibody.pdp.commerceCard.promotion.viewpromo']}}
{{$productOrderCtrl.translations['antibody.pdp.commerceCard.promotion.promocode']}}: {{promo.promoCode}} {{promo.promoTitle}} {{promo.promoDescription}}. {{$productOrderCtrl.translations['antibody.pdp.commerceCard.promotion.learnmore']}}
图: 1 / 2
SCN4A Antibody (PA5-101891) in IHC (P)


Please note: We are reviewing Western blot images included in the antibody testing data in our catalog, including those provided by third parties. Unless expressly labeled or annotated as “raw-unedited”, Western blot images included in the antibody testing data in our catalog may have been edited, optimized or otherwise adjusted for presentation.
产品信息
PA5-101891
种属反应
宿主/亚型
分类
类型
抗原
偶联物
形式
浓度
规格
纯化类型
保存液
内含物
保存条件
运输条件
RRID
产品详细信息
Antibody detects endogenous levels of total SCN4A.
靶标信息
Voltage-gated sodium channels are selective ion channels that regulate the permeability of sodium ions in excitable cells. During the propagation of an action potential, sodium channels allow an influx of sodium ions, which rapidly depolarize the cell. The three glycoproteins that comprise the voltagegated sodium channel proteins include a pore-forming alpha subunit, a noncovalently associated beta1 subunit and a disulfide-linked beta2 subunit. The two beta subunits regulate the level of channel expression, modulate gating and function as cell adhesion molecules for cellular aggregation and cytoskeleton interaction. The alpha subunits of sodium channels type I and III are predominantly expressed in neuronal cell bodies and proximal processes, while type II alpha subunits are more abundant along axons. The beta1 subunit of sodium channel type I is expressed in brain, skeletal and cardiac muscle. In the brain, beta1 and beta2 are highly expressed in Purkinje cells, and beta1 is also expressed in the pyramidal cells of the deep cerebellar nuclei. Impaired voltage-gated sodium channels lead to a number of diseases including myotonia.
仅用于科研。不用于诊断过程。未经明确授权不得转售。
篇参考文献 (0)
生物信息学
蛋白别名: hNaN; KIAA1356; MED; Mu-1; NAC1; NAC2; NAC3; Nav1.1; Nav1.2; Nav1.3; Nav1.5; Nav1.6; Nav1.7; Nav1.8; Nav1.9; NENA; SCN1; SCN10A; SCN11A; SCN12A; SCN1A; SCN2A; SCN2A1; SCN2A2; SCN3A; SCN5A; SCN8A; SCN9A; SkM1; SNS2; sodium channel alpha-subunit; Sodium channel protein skeletal muscle subunit alpha; Sodium channel protein type 4 subunit alpha; Sodium channel protein type IV subunit alpha; sodium channel voltage-gated type 4 alpha polypeptide; Sodium channel voltage-gated type IV alpha polypeptide; sodium channel, voltage-gated, type 4, alpha polypeptide; sodium channel, voltage-gated, type 4, alpha subunit; sodium channel, voltage-gated, type IV, alpha polypeptide; Voltage-gated sodium channel subunit alpha Nav1.4
基因别名: mH2; microI; Nav1.4; NCHVS; SCN4A; SkM1
UniProt ID: (Mouse) Q9ER60, (Rat) P15390
Entrez Gene ID: (Mouse) 110880, (Rat) 25722